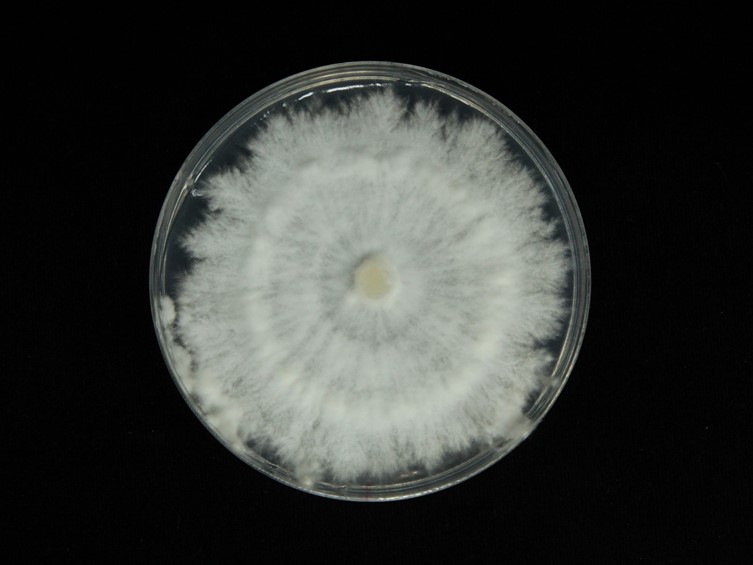

Description:
 Basidiomata 5-25 mm wide, 18-50 mm long, fan-shaped when attached to the side of the log, irregular to shell-shaped when attached above or below, upper surface covered with small hairs, dry, white to grayish or tan, under surface composed of gill-like folds that are split down the middle, whitish to grayish, without a stem, flesh tough, leathery, pallid. Lamellar brown. Peilipellis a cutis of elements 5-8 µm wide, thick-walled, branch. Hair hyphae 5-6 µm, pale brown, thick-walled.
Basidiomata 5-25 mm wide, 18-50 mm long, fan-shaped when attached to the side of the log, irregular to shell-shaped when attached above or below, upper surface covered with small hairs, dry, white to grayish or tan, under surface composed of gill-like folds that are split down the middle, whitish to grayish, without a stem, flesh tough, leathery, pallid. Lamellar brown. Peilipellis a cutis of elements 5-8 µm wide, thick-walled, branch. Hair hyphae 5-6 µm, pale brown, thick-walled.  Basidia 18-25 × 5-6 µm, 4 sterigmata, hyaline, clavate shaped. Cystidia absent. Clamp connections present. Spore print white.
Basidia 18-25 × 5-6 µm, 4 sterigmata, hyaline, clavate shaped. Cystidia absent. Clamp connections present. Spore print white.  Basidiospores 5-6.5 × 2-3 µm, hyaline, thin-walled, smooth, subcylindrical to cylindrical.
Basidiospores 5-6.5 × 2-3 µm, hyaline, thin-walled, smooth, subcylindrical to cylindrical.
Culture characteristics:
Spores germinated on PDA within 24 h. Colony was grown on PDA, white cottony,woolly of mycelium, reaching 5 cm in diam in 5–7 d at 25 °C, surface and reverse white to cream.
Colony was grown on PDA, white cottony,woolly of mycelium, reaching 5 cm in diam in 5–7 d at 25 °C, surface and reverse white to cream.
Reference:
Species |
Strain |
Compound |
Pubchem CID |
Biological activity |
Reference |
|---|
|
Strain |
|---|